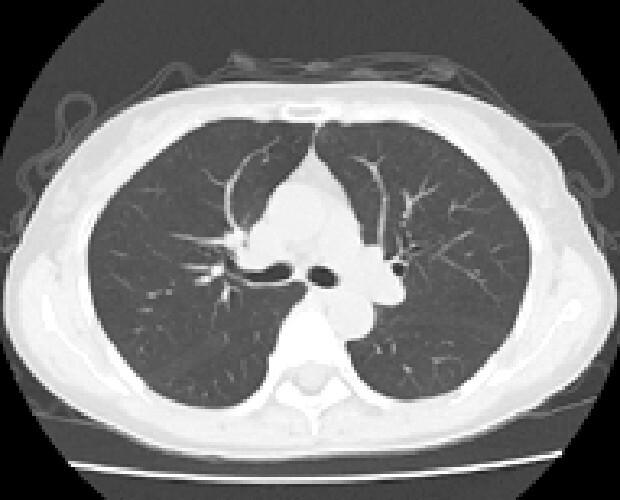

放射線科
放射線科
安全で質の高い画像検査のために
当院には一般撮影装置、CT、MRI、X線テレビ装置、骨密度測定装置などがあります。
機器紹介
MRI 1.5T

Canon製 MRI Vantage Elan

MRIとは
MRI装置は、磁力を使って体の様々な断面像を撮像しますので、放射線による被曝はありません。 また、頭部、四肢関節、脊椎、腹部、他全身の画像を撮像したり、造影剤を使用せずに血管・膵管・胆管等の情報を得ることもでき、全身の診断に大変効果があります。
本院のMRIシステムの特長
~最新のAI技術により「短い検査時間」または「3T相当の高画質」を実現します~
最新のAI技術であるディープラーニングを応用したノイズ除去技術を搭載しています。

3T相当のノイズの少ない画像を実現。また従来の1.5T装置と比較しても分解能を向上させることが可能です。

~患者様にやさしい装置です~
従来のMRI装置は、検査の時に工事現場のような激しい音がしていましたが、当院のMRI装置は、この検査時の音への緊張と不安をできるだけ取り除きました。従って、よりリラックスしながら安心して検査が受けられます。

CTスキャナ80列

Canon製 CT Aquilion Prime SP

マルチスライスCTスキャナは寝台に横になるだけで頭部・胸部・腹部など体内を断層(輪切り)で撮影できる検査です。
従来装置(64列)に比べて高速、高精度の撮影が可能なだけでなく、患者様の体型に合わせて線量を可変できるため適切なX線量で検査できます。
診断や治療のために骨や血管の3D(立体的な三次元画像)を作成することもできます。
デジタルX線テレビシステム




従来より高画質で低線量なデジタルX線テレビシステムです。透視検査では人体の透過像を動画で観察し、X線写真を撮影します。消化器から整形外科まで幅広い領域の画像検査に対応しています。
デジタルX線テレビシステム




骨密度測定器


50歳以上の女性の3人に1人は骨粗鬆症患者と言われています。
骨密度測定装置は極めて少ないX線を利用しているので、女性の方でも安心です。着衣のままベッドに仰向けになるだけで、痛みもなく簡単に測定できます。検査データは保存されますので、定期的な検査で正確な診断が行えます。
ご不明な点があれば、お気軽にお声かけ下さい。
医療機器共同利用について
当院では医療機器共同利用を行っています。特徴については以下ご参照ください。
医療機器共同利用とは?
- 検査のみを必要とする患者様に、当院の検査機器をご利用していただくシステムです。
- 検査のみとなりますので診察は行いません。
- 貴院にて診療報酬請求を行っていただきますので、当院での患者様支払はありません。
- 検査翌月もしくは翌々月に当院口座へ委託料をお振込みいただきます。
共同利用のメリット
- 機器導入に関わるイニシャルコストが不要
機器導入実費、電子カルテやPACSとの接続費用、保守費用等が必要ありません。 - 患者負担軽減
委託検査となりますので、紹介検査とは異なり患者さんの当院での初診料負担が不要となります。 - 読影レポートのご提供
放射線診断専門医による読影レポートをお付けいたします。お急ぎであれば当日FAX送信することも可能です。
共同利用の注意点
- 依頼元医療機関様でレセプト請求を行う必要があります。
- レセプト摘要欄に「八木病院と画診共同」とご記載下さい。
まずはお電話でご相談下さい︕
採用情報


